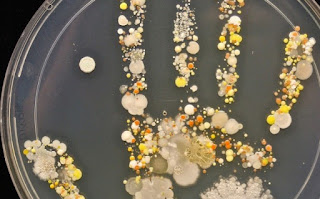

Λοιπόν, τώρα δεν χρειάζεται να το φαντάζεστε! Χάρη στην Tasha Sturm, μια επιστήμονα που εργάζεται στο εργαστήριο μικροβιολογίας υψηλής τεχνολογίας που βρίσκεται στο Cabrillo College, μπορείτε πλέον να δείτε την πραγματικότητα.
Η επιστήμονας έβαλε τον 8χρονο γιο της, ο οποίος μόλις είχε παίξει σε εξωτερικούς χώρους, να αφήσει ένα αποτύπωμα του χεριού του σε ένα τρυβλίο Petri, που ήταν γεμάτο με ζελέ άγαρ.
Μετά το έφερε σε θερμοκρασία σώματος σε ένα εκκολαπτήριο, με αποτέλεσμα τα βακτήρια και οι μύκητες από το χέρι του γιου της να μεγαλώσουν σε καλλιέργειες.
Στη συνέχεια, μέσω του εργαστηριακού εξοπλισμού κατάφερε να αποτυπώσει όλες τις λεπτομέρειες σε φωτογραφίες, τις οποίες δημοσίευσε στο περιοδικό Microbe World.
Η εικόνα είναι όμορφη από την μια και από την άλλη σου γυρίζει το στομάχι ανάποδα! Σε κάνει να σκέφτεσαι «Πρέπει να πάω να πλύνω τα χέρια μου αμέσως»!
Αλλά μην ανησυχείτε! Όπως δήλωσε η επιστήμονας «Είναι συνηθισμένα πράγματα στα οποία είμαστε εκτεθειμένοι κάθε μέρα. Το δέρμα, μας προστατεύει από πολλά από τα κακά πράγματα εκεί έξω. Το μήνυμα είναι ότι το για να έχουμε ένα υγιές ανοσοποιητικό σύστημα.., πρέπει να εκτιθέμεθα σε όλα αυτά τα «αηδιαστικά» καθημερινά πράγματα.»
Συνεπώς, συνεχίστε να ζείτε «βρώμικα», παιδιά!
Συνεπώς, συνεχίστε να ζείτε «βρώμικα», παιδιά!